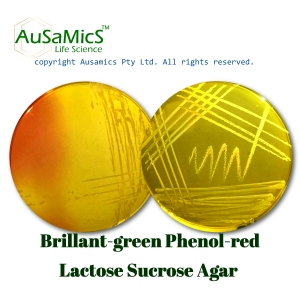
BPLS_Ausamics
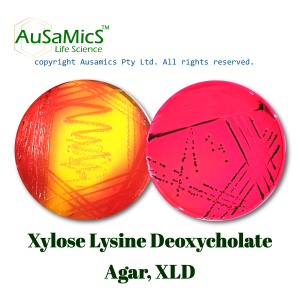
XLD_Ausamics
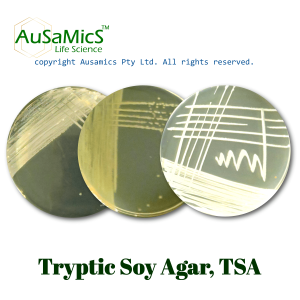
TSA_Ausamics
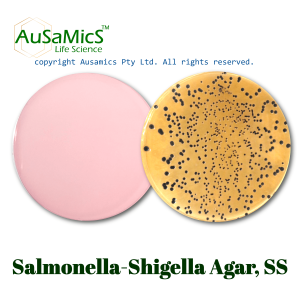
SS_Agar1_Ausamics

Casein-peptone Lecithin Polysorbate Broth Base, TAT Broth
Used for cultivating microorganisms from highly viscous or gelatinous materials (with added polysorbate 20).
- Description
- Composition
- Quality Control
- Microbial Test Results
Casein peptone lecithin polysorbate broth base, also known as TAT Broth, is a neutralizing broth that is mostly used for sample dilution in cosmetics, pharmaceuticals, and other related fields. The medium is developed to facilitate the recovery of injured microorganisms by providing the best conditions possible for their development and recovery.
A rich amount of nutrients is provided by the addition of casein peptone, which aids in the healing of injured cells. To neutralize different antimicrobial substances like phenols and quaternary ammonium compounds, lecithin and polysorbate 20 work as neutralizing agents. Since thioglycolate can obstruct the inactivation of some preservatives, it is purposefully left out.
Storage
Keep the container at 15-30 °C and prepared medium at 2-8 °C.
| Composition | gr/L |
| Pancreatic Digest of Casein | 20 |
| Soy Lecithin | 5 |
| Final pH at 25°C | 7.2 ± 0.2 |
| Dehydrated Appearance | Beige, free-flowing, homogeneous. |
| Prepared Appearance | Light amber, clear to very slightly opalescent, may have a very slight precipitate. |
| Reaction of 2.5% Solution at 25°C | pH 7.2 ± 0.2 |
| Incubate at 35 ± 2 °C for 18 to 48 hours. | |
| Organism (ATCC) | Recovery |
| Bacillus subtilis (6633) | Good |
| Candida albicans (26790) | Fair to Good |
| Pseudomonas aeruginosa (27853) | Good |
| Staphylococcus aureus (25923) | Good |